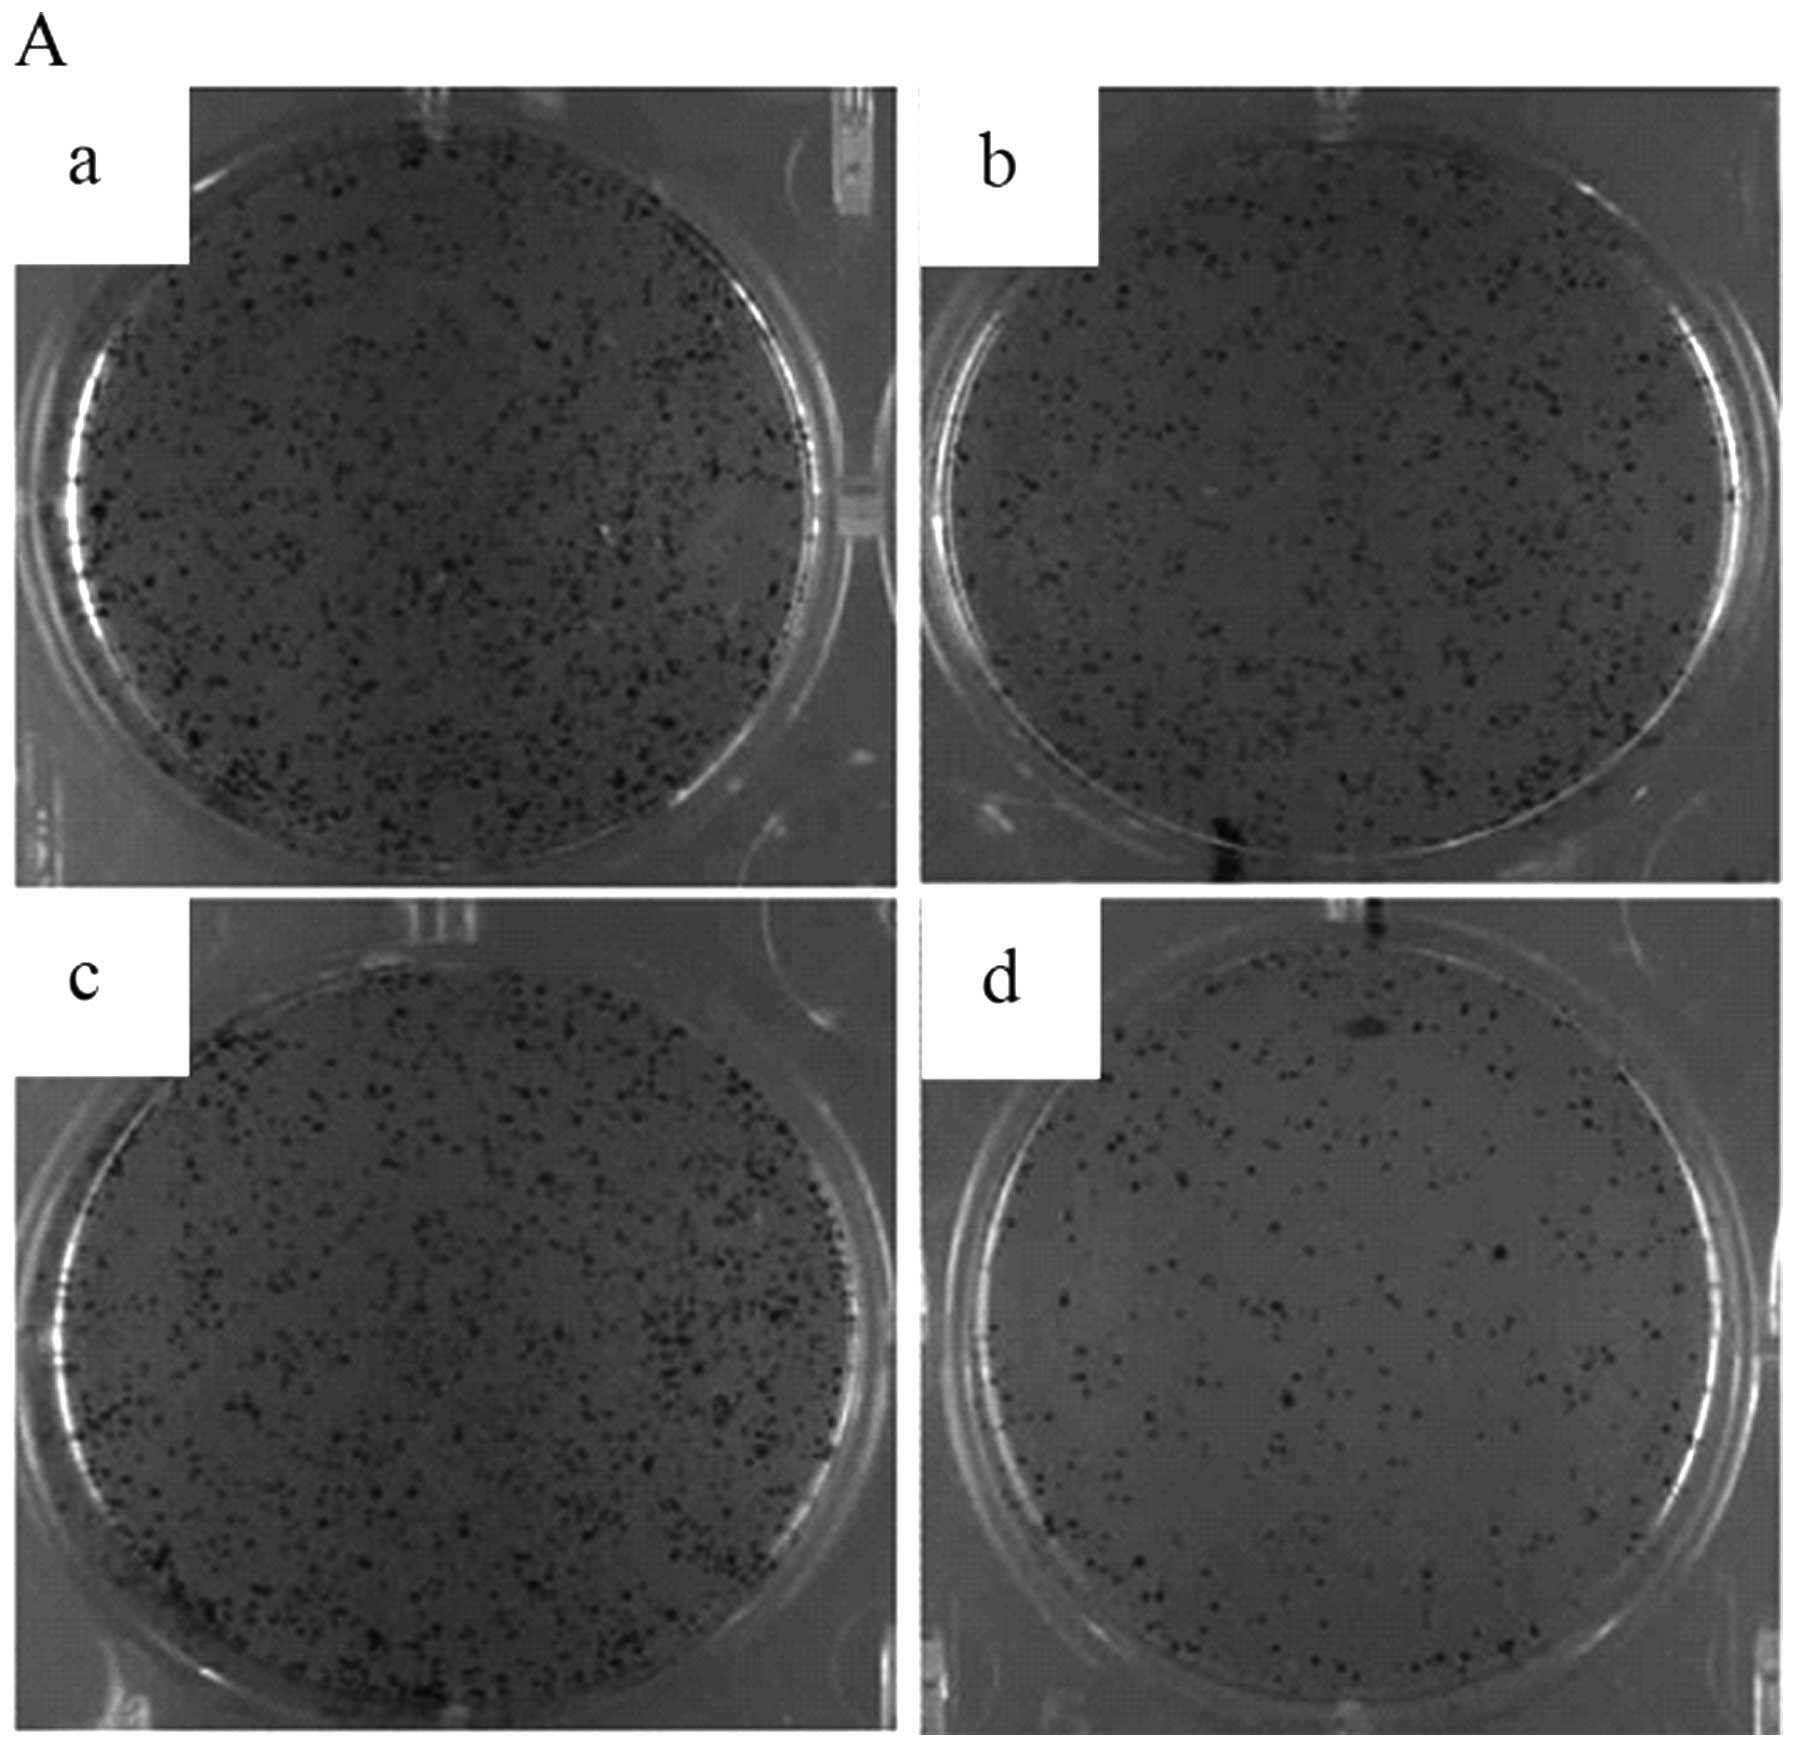

Introduction
Hepatocellular carcinoma (HCC) is one of the leading
causes of cancer-related mortality worldwide (1), and despite the extensive application
of intensive surveillance programs, considerable therapeutic
progress, and technological improvement observed over the past few
years, prognosis of this tumor remains poor due to the high
recurrence rate and metastatic potential of HCC cells, even when
treatments have been considered potentially curative (2,3). The
incidence of intrahepatic or extrahepatic metastases is high in HCC
with an infiltrative growth pattern according to clinicopathologic
study (4). However, there is no
effective chemotherapeutic agent which prevents recurrence and
metastasis in HCC patients.
The A disintegrin and metalloproteinase (ADAM)
family is a class of type I transmembrane proteins that contain two
main structural domains: the disintegrin domain and the matrix
metalloproteinase domain. Members of the ADAM family function as
sheddases by cleaving type I and type II integral single membrane
proteins to generate soluble forms of these proteins (5) and have been found to be involved in
the etiologies of a variety of diseases and conditions (6–8).
Members of the ADAM family can degrade the extracellular matrix
(ECM) and control cell adhesion and movement through regulation of
intercellular adhesion, protease activity and cell activities that
are closely related to the metastasis of human tumors (9,10). To
date, 13 catalytically active ADAMs have been identified in the
human genome (11,12). One member of the ADAM family, A
disintegrin and metalloproteinase 10 (ADAM10), has recently been
reported to play important roles in cell migration, tumor
development and metastasis by proteolytic shedding of cell surface
proteins and has been demonstrated to be a positive regulator of
cancer progression in renal cell carcinoma (13), pancreatic carcinoma (14), lung cancer (15), gastric carcinoma (16), oral squamous cell carcinoma
(17) and melanoma (18). Proteolytically active ADAM10 acts as
an ectodomain sheddase, which releases extracellular regions of
membrane-bound proteins (e.g., adhesion molecules, growth factors,
cytokines, chemokines and receptors). Through these actions it is
able to sculpt the tumor microenvironment and modulate key
processes involved in cancer progression, including cell
proliferation, migration and angiogenesis (19). The emerging role of ADAM10 as a
significant contributor to these pathologies has led to its intense
interest as a potential drug target for tumor treatment (6). However, ADAM10 expression in HCC and
its significance in HCC progression remain largely unknown. In the
present study, we investigated the expression of ADAM10 in human
HCC tissues and the adjacent non-cancerous tissues from 30 HCC
patients using immunohistochemistry. Moreover, the effects of
ADAM10 gene silencing by siRNA on the proliferation, invasion and
migration of HepG2 human hepatoma cells were observed in
vitro.
Materials and methods
Ethics statement
The study was approved by the Ethics Committee of
the First Affiliated Hospital of Xi’an Jiaotong University. All
experiments were performed in accordance with the principles of the
Declaration of Helsinki. All participants provided their written
informed consent to participate in the study.
Patient information
A total of 30 HCC patients who were treated with
partial liver resection surgery at the Department of Hepatobiliary
Surgery of the First Affiliated Hospital of Xi’an Jiaotong
University from 2008 to 2011 were enrolled in this study. These
patients included 24 males and 6 females, with a mean age of 53.16
years (range, 34–73 years). The patients were pathologically
diagnosed with HCC at histological grade I (n=4), grade II (n=19)
and grade III (n=7), and classified as stage I (n=7), stage II
(n=17) and stage III (n=6). Histological grading and staging were
according to the modified nuclear grading scheme outlined by the
Edmondson and Steiner and Okuda system, respectively (20,21).
No prior treatments (including chemotherapy or radiotherapy) were
conducted before liver resection surgery.
Tissue samples and cell lines
The paraffin-embedded HCC tissues and the
corresponding non-cancerous tissues from the 30 patients mentioned
above were collected for pathological analysis. The human hepatoma
cell line HepG2 was obtained from the Center of Biomedical
Experimental Research at the Medical School, Xi’an Jiaotong
University.
Immunohistochemical staining
Immunohistochemical staining was performed using
streptavidin-peroxidase technique, and diaminobenzidine (DAB) was
used as a chromogen. Rabbit polyclonal antibody against human
ADAM10 protein was obtained from Santa Cruz Biotechnology, Inc.
(Santa Cruz, CA, USA). The primary antibody for the negative
control group was replaced with PBS. Five representative high-power
fields (x400 magnification) for each tissue section were selected
for histological evaluation. Two parameters, positive rate (PR) and
staining intensity (SI), were used to describe the expression based
on the extent and intensity of positively stained cells in the
samples. PR is the percentage of positively stained cells in the
tissues: ≤10% stained cells was defined as negative (scored as 0),
11–30% stained cells was defined as positive with low frequency
(scored as 1), 31–60% stained cells was defined as positive with
medium frequency (scored as 2), and >60% stained cells was
defined as positive with high frequency (scored as 3). SI is the
ranked staining intensity of positively stained cells in the
samples, which ranged from 0 to 3, dim positive, mediate positive
and strong positive, respectively. Since the expression of the
protein was comprehensively evaluated based on both extent and
intensity, the sum of both parameters provide the final scores for
ADAM10 in each sample, in which the final score <4 was defined
as low/negative expression, and the final score ≥4 was defined as
high expression.
Cell culture
HepG2 cells were cultured in Dulbecco’s modified
Eagle’s medium (DMEM) (Invitrogen Life Technologies, Carlsbad, CA,
USA) containing 10% fetal bovine serum (FBS) and 1%
penicillin/streptomycin (Invitrogen Life Technologies) and
incubated at 37ºC in an atmosphere containing 5%
CO2.
siRNA transfection
For downregulation of endogenous ADAM10 expression,
the following siRNA duplex (Aoke Biological Technology Co., Ltd.,
Shanghai, China) was used: 5′-AGACAUUAUGAAGGAUUAUTT-3′. As a
negative control, the unspecific scrambled siRNA duplex
(5′-AGGUAGUGUA AUCGCCUUGTT-3′) was used.
At 24 h before transfection, 1×105 HepG2
cells were seeded in 6-well plates. Transfection of siRNA was
carried out using Lipofectamine 2000 (Invitrogen Life Technologies)
and 10 nM siRNA duplex/well. Transfection was performed as
previously described (18).
Specific silencing of targeted genes was confirmed by at least 3
independent experiments.
Four groups were established in this study: blank
control group, Lipo2000 group (cells were treated with
Lipofectamine 2000), control siRNA group (cells were treated with
Lipofectamine 2000 plus the negative control siRNA), and
ADAM10-siRNA group (cells were treated with Lipofectamine 2000 plus
ADAM10 siRNA).
Real-time RT-PCR
Real-time RT-PCR for ADAM10 transcripts in HepG2
cells was carried out using the PrimeScript RT reagent kit
following the manufacturer’s instructions (Takara Bio, Inc., Shiga,
Japan). ADAM10 gene-specific amplification was confirmed by PCR
with specific primers (5′-CTGCCCAGCATCTGACCCTAA-3′ and 5′-TTGCCATC
AGAACTGGCACAC-3′) and subjected to melting curve analysis. GAPDH
was used as an internal control for standardization. All RT-PCR
tests were performed in triplicate. The data were analyzed using
the comparative Ct method.
Western blot analysis
Cells were washed twice with cold phosphate-buffered
saline (PBS; 137 mM NaCl, 2.7 mM KCl, 10 mM sodium phosphate
dibasic, 2 mM potassium phosphate monobasic, pH 7.4) and lysed on
ice in buffer (150 mM NaCl, 50 mM Tris-HCl, 2 mM EDTA, 1% NP-40, pH
7.4) containing protease inhibitors. Equal amounts of protein (20
μg/lane) from the cell lysates were electrophoresed under
non-reducing conditions on 10% acrylamide gels. After SDS-PAGE,
proteins were transferred to a polyvinylidene difluoride membrane.
The membrane was incubated for 2 h in PBS plus 0.1% Tween-20 and 5%
nonfat skim milk to block nonspecific binding. Subsequently, the
membrane was incubated for 2 h with an antibody against ADAM10
(R&D Systems, Minneapolis, MN, USA). After washing, proteins
were visualized using an ECL detection kit with the appropriate
HRP-conjugated secondary antibody (Amersham Pharmacia Biotech,
Piscataway, NJ, USA). The membranes were stripped and probed with
monoclonal antibodies for GAPDH for the loading control as per
standard protocols.
Proliferation assay
The
3-[4,5-dimethylthiazol-2-yl]-2,5-diphenyltetrazolium bromide (MTT)
(Sigma Corporation, USA) colorimetric assay was used to screen for
cell proliferation. Briefly, HepG2 cells were seeded into eight
96-well plates at a density of 2×103 cells/well and
incubated in RPMI-1640 medium for 24, 48, 72 and 96 h after
treatment, respectively. Twenty microliters of MTT (5 mg/ml) was
added into each well, and the cell culture was continued for 4 h.
After aspiration of the medium, the cells were lysed with DMSO
(Sigma Corporation). The absorbance was measured using a microplate
reader at a wavelength of 490 nm. The cell growth curve was plotted
with OD values as the ordinate against time as the abscissa. The
experiment was repeated 3 times.
Soft agar colony formation assay
Briefly, 4×103 HepG2 cells were mixed
with 0.5% top agar and seeded on 24-well plates with 1% base agar.
These cells were then cultured in an incubator with 5%
CO2 and 95% humidity at 37ºC for 10 days. Finally, the
cell colonies in soft agar were photographed and counted by a
microscope. All of the experiments were independently repeated at
least 3 times.
Cell migration assay
The effect of ADAM10 knockdown on HepG2 cell
migration was measured as the ability of cells to migrate through
Transwell filters (6.5-mm diameter, 5-μm pore size). Transwell
filters were coated with Matrigel for 1.5 h before adding the
cells. At 24 h after the siRNA transfection, cells were detached by
trypsinization, and 1×105 cells were seeded into
Transwell filters in 100 ml of starvation medium. Growth medium
(500 ml) was placed in the lower compartment, and the cells were
left to migrate for 24 h. Non-migratory cells were removed by a
cotton swab, and the transmigrated cells at the backside of the
filter were stained with Giemsa. HepG2 cells on each filter were
counted at x400 magnification to quantitate HepG2 cell migration.
Images of 3 random fields from 3 replicate wells were obtained.
Migration was determined as the mean of the cells that had migrated
per x400 field and was expressed as a percentage of the blank
control.
In vitro invasion assay
HepG2 cell invasive behavior was evaluated using
24-well Transwell units with 8-μm porosity polycarbonate filters.
The filters were coated with 50 μl of 8 mg/ml reconstituted
basement membrane substance (Matrigel; BD Biosciences, San Diego,
CA, USA). The coated filters were air-dried at 4ºC prior to the
addition of the cells. The basement membrane was hydrated with 50
μl serum-free RPMI-1640 medium 30 min before use. The cells were
digested with trypsin, and the cell density was adjusted to
1×106/ml using serum-free RPMI-1640 medium. A total of
200 μl of cell suspension was added into each upper Transwell
chamber, and 600 μl of RPMI-1640 medium containing 5% fetal bovine
serum was added into the lower chamber. There were three duplicates
for each cell group. The cells were then incubated for 24 h in a
humidified atmosphere of 5% CO2 at 37ºC. Cells were
fixed with methanol and stained with Giemsa. Cells on the upper
surface of the filter were removed by wiping with a cotton swab,
and invasion was determined by counting the cells that migrated to
the lower side of the filter with optical microscopy at x400
magnification. A total of 5 visual fields at the center and in the
surrounding areas was counted, and the average was calculated
(22). The experiment was repeated
3 times.
Data and statistical analysis
All data are presented as the means ± standard error
of the mean. Statistical analysis was performed using SPSS 16.0
software. Differences among groups were tested by one-way analysis
of variance (ANOVA). A P-value <0.05 was considered to indicate
a statistically significant result.
Results
Expression of ADAM10 protein in paired
HCC and corresponding non-cancerous tissue samples
ADAM10 was detected in 22 out of 30 (73.33%) HCC
tissues and in only 1 out of the 30 (3.33%) corresponding
non-cancerous tissues (Fig. 1). The
frequency of ADAM10 in HCC tissues was significantly higher than
that in the non-cancerous tissues (P<0.05).
Increase in ADAM10 expression correlates
with worse prognosis and shorter survival of patients after
surgery
All of the 30 patients were completely followed up.
During follow-up, 13 patients died, whereas 17 patients were alive
at the end of the study. The median follow-up period was 28 months
(3–45 months). The median survival time was 22.3 months (95% CI,
20.09–26.46). We compared the expression of ADAM10 in the patients
according to different gender, age, status of HBV infection,
history of alcohol consumption and smoking, disease stage,
histological differentiation, microvascular invasion and clinical
outcome. The levels of ADAM10 expression did not significantly vary
between males and females, elderly and younger, and HBV infected
and uninfected patients. No significant difference was identified
between patients with and without a history of alcohol consumption
or smoking. The expression levels of ADAM10 did correlate with the
clinical outcomes although the level did not vary significantly
among HCC samples at different clinical stages, degree of
histological differentiation and microvascular invasion. It was
observed that 12 of the 13 HCC patients who passed away had tumors
with high ADAM10 expression. This percentage was significantly
higher than the percentage in the living HCC patients (92.31 vs.
58.82%, P=0.040, Table I). Using
the Kaplan-Meier method, the overall survival rates were estimated
for the 30 patients. Overall survival was significantly shorter in
the ADAM10 high expression group than that in the ADAM10
low/negative expression group (p=0.044) (Fig. 2). This result implies that high
expression of ADAM10 may be a valuable predictive factor for HCC
prognosis.
 | Table ICorrelation between the expression of
ADAM10 in the 30 cases of HCC tissues and multiple
clinicopathological features of the corresponding patients. |
Table I
Correlation between the expression of
ADAM10 in the 30 cases of HCC tissues and multiple
clinicopathological features of the corresponding patients.
| | Expression of
ADAM10 | |
|---|
| |
| |
|---|
| Features | Case | − | + | P-value |
|---|
| Gender |
| Female | 6 | 2 | 4 | 0.680 |
| Male | 24 | 6 | 18 | |
| Age (years) |
| <53.16 | 14 | 6 | 8 | 0.061 |
| ≥53.16 | 16 | 2 | 14 | |
| HBV infection |
| No | 4 | 1 | 3 | 0.935 |
| Yes | 26 | 7 | 19 | |
| Alcohol
history |
| No | 13 | 5 | 8 | 0.201 |
| Yes | 17 | 3 | 14 | |
| Smoking
history |
| No | 22 | 5 | 17 | 0.418 |
| Yes | 8 | 3 | 5 | |
| Clinical stage of
disease |
| I | 7 | 2 | 5 | 0.889 |
| II | 17 | 4 | 13 | |
| III | 6 | 2 | 4 | |
| Histological
grade |
| I | 4 | 2 | 2 | 0.488 |
| II | 19 | 4 | 15 | |
| III | 7 | 2 | 5 | |
| Microvascular
invasion |
| Presence | 12 | 4 | 8 | 0.396 |
| Absence | 18 | 4 | 14 | |
| Clinical
outcome |
| Alive | 17 | 7 | 10 | 0.040 |
| Deceased | 13 | 1 | 12 | |
Knockdown of ADAM10 in HepG2 cells
The expression of ADAM10 was examined by real-time
RT-PCR and western blotting to validate the silencing efficiency of
the target gene after RNAi. Stable ADAM10 siRNA-transfected HepG2
cells (ADAM10-siRNA) and a mock-transfected control cell line
(control siRNA) were established as described above. Compared to
the parental HepG2 cells and control siRNA cells, both mRNA and
protein expression of ADAM10 was significantly reduced in the
ADAM10 siRNA cells at 24 h after siRNA transfection (all P<0.05;
Fig. 3A and B), which persisted for
at least 96 h (data not shown).
Gene silencing of ADAM10 reduces cell
proliferation and cell colony formation in HepG2 cells
To examine whether the knockdown of ADAM10
expression had any affect on cell growth, an MTT cell proliferation
assay was performed. Compared to the blank control group, the
Lipo2000 group, and the control siRNA group cells, ADAM10-siRNA
group cells showed decreased cell proliferation, supporting the
role of ADAM10 in cell growth in HepG2 cells (P<0.05, Fig. 4). In addition, the affect of gene
silencing of ADAM10 on the cell colony formation of HepG2 cells was
also investigated by a soft agar colony formation assay. The
results indicated that the cell colony number significantly
decreased in the ADAM10-siRNA group compared to the blank control
group, Lipo2000 group, and control siRNA group (P<0.05, Fig. 5A and B).
Gene silencing of ADAM10 reduces cell
migration in HepG2 cells
The effect of gene silencing of ADAM10 on the cell
migration ability of HepG2 cells was investigated by Transwell
invasion assay (Fig. 6A). The
results indicated that ADAM10 siRNA cells had a significantly
reduced ability to pass through the basement membrane when compared
to the cells in the other 3 groups (all P<0.05; Fig. 6B). These data support the notion
that ADAM10 expression is essential for cell migration.
Gene silencing of ADAM10 reduces the
invasive ability of HepG2 cells
The invasive ability of HepG2 cells was investigated
using a Matrigel invasion assay. The invasion assay results
indicated that HepG2 cells had a significantly lower ability to
pass through the basement membrane compared to the cells in the
other three groups (all P<0.05; Fig.
7A and B). These results indicate that ADAM10 plays a key role
in hepatocarcinoma cell invasion.
Discussion
Various members of the ADAM family including ADAM10
have been shown to be overexpressed in malignant tumors and may be
related to the biological behavior. For example, downregulation of
ADAM10 has been shown to suppress cell proliferation and decrease
the metastatic potential of adenoid cystic carcinoma cells
(23). We hypothesized that the
expression of ADAM10 is increased in HCC and their downregulation
of ADAM10 may influence the biological behavior of HepG2 cells.
However, previous reports that may relate to this hypothesis are
scarce. Thus, the purpose of this study was to evaluate the
expression of ADAM10 in HCC tissues and adjacent non-tumor tissues
and to analyze the relationship between the gene silencing of
ADAM10 and the proliferation, invasion and migration capability of
HepG2 cells in vitro.
In this study, we characterized the expression of
ADAM10 in HCC tissues. Immunohistochemical analysis indicated that
ADAM10 expression was significantly elevated in HCC tissues when
compared to that in the adjacent non-tumor tissues, suggesting that
ADAM10 may be associated with hepatocarcinogenesis. Further
survival analysis demonstrated that the high expression of ADAM10
in HCC was significantly correlated with worse prognosis and
shorter survival of patients following surgery, suggesting that
high expression of ADAM10 may be a valuable predictive factor for
HCC prognosis.
Currently, surgery is the preferred treatment method
for liver cancer, yet the 5-year survival rate remains extremely
low due to the high recurrence rate and the metastatic potential of
HCC cells. It is reported that up to 70% of the patients show
relapse within 5 years after curative resection (24). Autopsy studies confirm that nearly
one-third of all HCC patients have lymph node metastasis, which is
the leading cause for distant metastasis and mortality (25). In other studies, overexpression of
ADAM10 has been demonstrated to be a potential prognostic indicator
for high risk of recurrence and metastasis (18,23,26).
Based on these data, it is reasonable to speculate that ADAM10 may
play a role in HCC growth and metastasis.
To provide evidence supporting this supposition, we
investigated the effects of ADAM10 silencing on the proliferation,
invasion and migration of human hepatoma HepG2 cells in
vitro. The expression of ADAM10 was specifically knocked down
in the human HepG2 cell line using RNAi. Downregulation of ADAM10
resulted in suppression of tumor cell proliferation, which strongly
supports that ADAM10 is involved in the process of tumor
development. Our data are in line with previous reports showing
that ADAM10 expression is correlated with the proliferation of
tumor cells. Ko et al(17)
demonstrated that the expression of ADAM10 was correlated with
increased growth of oral squamous cell carcinoma cells. Arima et
al(27) confirmed that
suppression of ADAM10 expression leads to a significant decrease in
prostate cancer cell growth. The effect of ADAM10 on tumor cell
growth may be related to its protease activity. ADAM10 can cleave
several critical transmembrane molecules including amyloid
precursor protein (28,29). It must be noted that soluble amyloid
precursor protein has been related to the growth of several types
of cells (30,31), which suggests that ADAM10 may
influence the proliferation of HepG2 cells via amyloid precursor
protein shedding.
In addition, in the present study, the transfection
of ADAM10 siRNA resulted in a significant reduction in cellular
invasion and migration of HepG2 cells, which strongly indicates
that ADAM10 is involved in the process of HCC metastasis. Our
finding is in agreement with previous reports on the functional
roles of ADAM10. Biological behaviors of cancer cells are regulated
by multiple growth factors and cytokines. Many cytokines and growth
factors involved in this process are synthesized as membrane bound
proforms which undergo proteolytic shedding for activation. ADAM10
is one of the representative proteases that mediate proteolytic
shedding, and this process appears to be involved in the
pathophysiology of various diseases such as cancer (9). Tumor metastasis is dependent on the
ability of the tumor to degrade the surrounding ECM and reduced
cell adhesion. Studies have demonstrated that ADAM10 can cleave and
remodel ECM proteins such as CD44. Pan et al(32) found that in the pituitary adenoma
cell line, AtT-20, ADAM10 facilitated cell migration through
modulation of CD44 and L1 cleavage. In another study, Anderegg
et al(33) showed that
ADAM10 is the predominant protease involved in the constitutive
shedding of endogenous CD44 from melanoma cells. Multiple cell
signaling pathways are responsible for cellular proliferation and
migration (34). ADAM10 may also
promote tumor metastasis by influencing cell-cell signaling.
E-cadherin is a transmembrane molecule which functions as an
adhesion molecule. Increased expression of ADAM10 may lead to
elevated shedding of E-cadherin and loss of cell-cell contact
(18). Expression levels of several
components of the Notch pathway, which can be cleaved by ADAM10,
were upregulated in melanomas compared with common melanocytic nevi
(35). Guo et al(15) presented further evidence that ADAM10
promotes non-small cell lung cancer (NSCLC) cell migration and
invasion via the activation of the Notch1 signaling pathway. In
another study, Gutwein et al(36) demonstrated that the release of
cell-associated adhesion molecules such as L1 may be relevant to
promote cell migration, and L1 release in AR breast carcinoma cells
is mediated by ADAM10. Taken together, ADAM10 is able to modulate a
variety of cell-cell and cell-ECM interactions and can consequently
digest the basement membrane, facilitate cell migration and promote
tumor metastasis. Importantly, in the present study, we discovered
that downregulation of ADAM10 via ADAM10-specific siRNA
significantly inhibited the proliferation, invasion and migration
capability of HepG2 cells, which suggests that ADAM10 is a
promising new therapeutic target for the treatment of HCC. In the
future, studies using undifferentiated and aggressive
hepatocarcinoma cell lines with metastatic potential, such as
MHCC97-H and SNU398 may be used to further reveal the role of
ADAM10 in hepatocarcinogenesis and HCC progression.
In conclusion, our data revealed that ADAM10
expression in HCC tissues was significantly higher than that in
adjacent non-tumor tissues. High expression of ADAM10 may be a
valuable predictive factor for HCC prognosis. Reduced ADAM10
expression not only impacted cell proliferation, but also decreased
the metastatic potential of HepG2 cells, indicating that ADAM10 may
participate in hepatocarcinogenesis and HCC progression. Thus,
ADAM10 is a potential therapeutic target for the treatment of
HCC.
Acknowledgements
The authors thank Dr Zuoren Wang for review of the
manuscript and the helpful comments.
References
|
1
|
El-Serag HB: Hepatocellular carcinoma. N
Engl J Med. 365:1118–1127. 2011. View Article : Google Scholar : PubMed/NCBI
|
|
2
|
Bruix J and Sherman M; American
Association for the Study of Liver Diseases. Management of
hepatocellular carcinoma: an update. Hepatology. 53:1020–1022.
2011. View Article : Google Scholar : PubMed/NCBI
|
|
3
|
Wang N, Feng Y, Lau EP, et al: F-actin
reorganization and inactivation of rho signaling pathway involved
in the inhibitory effect of Coptidis Rhizoma on hepatoma
cell migration. Integr Cancer Ther. 9:354–364. 2010. View Article : Google Scholar : PubMed/NCBI
|
|
4
|
Kanai T, Hirohashi S, Upton MP, et al:
Pathology of small hepatocellular carcinoma. A proposal for a new
gross classification. Cancer. 60:810–819. 1987. View Article : Google Scholar : PubMed/NCBI
|
|
5
|
Saftig P and Reiss K: The ‘A Disintegrin
And Metalloproteases’ ADAM10 and ADAM17: novel drug targets with
therapeutic potential? Eur J Cell Biol. 90:527–535. 2011.
|
|
6
|
Crawford HC, Dempsey PJ, Brown G, Adam L
and Moss ML: ADAM10 as a therapeutic target for cancer and
inflammation. Curr Pharm Des. 15:2288–2299. 2009. View Article : Google Scholar : PubMed/NCBI
|
|
7
|
Postina R, Schroeder A, Dewachter I, et
al: A disintegrin-metalloproteinase prevents amyloid plaque
formation and hippocampal defects in an Alzheimer disease mouse
model. J Clin Invest. 113:1456–1464. 2004. View Article : Google Scholar
|
|
8
|
Naus S, Blanchet MR, Gossens K, Zaph C,
Bartsch JW, McNagny KM and Ziltener HJ: The
metalloprotease-disintegrin ADAM8 is essential for the development
of experimental asthma. Am J Respir Crit Care Med. 181:1318–1328.
2010. View Article : Google Scholar : PubMed/NCBI
|
|
9
|
Murphy G: The ADAMs: signalling scissors
in the tumour microenvironment. Nat Rev Cancer. 8:929–941. 2008.
View Article : Google Scholar : PubMed/NCBI
|
|
10
|
Lu X, Lu D, Scully M and Kakkar V: ADAM
proteins - therapeutic potential in cancer. Curr Cancer Drug
Targets. 8:720–732. 2008. View Article : Google Scholar : PubMed/NCBI
|
|
11
|
Becherer JD and Blobel CP: Biochemical
properties and functions of membrane-anchored
metalloprotease-disintegrin proteins (ADAMs). Curr Top Dev Biol.
54:101–123. 2003. View Article : Google Scholar : PubMed/NCBI
|
|
12
|
Huang J, Bridges LC and White JM:
Selective modulation of integrin-mediated cell migration by
distinct ADAM family members. Mol Biol Cell. 16:4982–4991. 2005.
View Article : Google Scholar : PubMed/NCBI
|
|
13
|
Doberstein K, Pfeilschifter J and Gutwein
P: The transcription factor PAX2 regulates ADAM10 expression in
renal cell carcinoma. Carcinogenesis. 32:1713–1723. 2011.
View Article : Google Scholar : PubMed/NCBI
|
|
14
|
Gaida MM, Haag N, Günther F, et al:
Expression of A disintegrin and metalloprotease 10 in pancreatic
carcinoma. Int J Mol Med. 26:281–288. 2010.PubMed/NCBI
|
|
15
|
Guo J, He L, Yuan P, et al: ADAM10
overexpression in human non-small cell lung cancer correlates with
cell migration and invasion through the activation of the Notch1
signaling pathway. Oncol Rep. 28:1709–1718. 2012.PubMed/NCBI
|
|
16
|
Wang YY, Ye ZY, Li L, Zhao ZS, Shao QS and
Tao HQ: ADAM 10 is associated with gastric cancer progression and
prognosis of patients. J Surg Oncol. 103:116–123. 2011. View Article : Google Scholar : PubMed/NCBI
|
|
17
|
Ko SY, Lin SC, Wong YK, Liu CJ, Chang KW
and Liu TY: Increase of disintergin metalloprotease 10 (ADAM10)
expression in oral squamous cell carcinoma. Cancer Lett. 245:33–43.
2007. View Article : Google Scholar : PubMed/NCBI
|
|
18
|
Lee SB, Schramme A, Doberstein K, et al:
ADAM10 is upregulated in melanoma metastasis compared with primary
melanoma. J Invest Dermatol. 130:763–773. 2010. View Article : Google Scholar : PubMed/NCBI
|
|
19
|
Turner SL, Blair-Zajdel ME and Bunning RA:
ADAMs and ADAMTSs in cancer. Br J Biomed Sci. 66:117–128.
2009.PubMed/NCBI
|
|
20
|
Pawlik TM, Gleisner AL, Anders RA,
Assumpcao L, Maley W and Choti MA: Preoperative assessment of
hepatocellular carcinoma tumor grade using needle biopsy:
implications for transplant eligibility. Ann Surg. 245:435–442.
2007. View Article : Google Scholar
|
|
21
|
Okuda K, Ohtsuki T, Obata H, et al:
Natural history of hepatocellular carcinoma and prognosis in
relation to treatment. Study of 850 patients. Cancer. 56:918–928.
1985. View Article : Google Scholar : PubMed/NCBI
|
|
22
|
Yu Y, Chen W, Zhang Y, Hamburger AW, Pan H
and Zhang Z: Suppression of salivary adenoid cystic carcinoma
growth and metastasis by ErbB3 binding protein Ebp1 gene transfer.
Int J Cancer. 120:1909–1913. 2007. View Article : Google Scholar : PubMed/NCBI
|
|
23
|
Xu Q, Liu X, Chen W and Zhang Z:
Inhibiting adenoid cystic carcinoma cell growth and metastasis by
blocking the expression of ADAM 10 using RNA interference. J Transl
Med. 8:1362010. View Article : Google Scholar : PubMed/NCBI
|
|
24
|
Llovet JM, Schwartz M and Mazzaferro V:
Resection and liver transplantation for hepatocellular carcinoma.
Semin Liver Dis. 25:181–200. 2005. View Article : Google Scholar : PubMed/NCBI
|
|
25
|
Zhu W, Owusu L, Zang S, Zhang Y, Xin Y and
Yan C: GRP78 and GAL3, differentially regulated by lymph node
homogenates, as potential biomarkers for lymph node metastasis in
mouse hepatocellular carcinoma cells. Oncol Lett. 4:1374–1378.
2012.PubMed/NCBI
|
|
26
|
Gavert N, Conacci-Sorrell M, Gast D,
Schneider A, Altevogt P, Brabletz T and Ben-Ze’ev A: L1, a novel
target of β-catenin signaling, transforms cells and is expressed at
the invasive front of colon cancers. J Cell Biol. 168:633–642.
2005.
|
|
27
|
Arima T, Enokida H, Kubo H, et al: Nuclear
translocation of ADAM-10 contributes to the pathogenesis and
progression of human prostate cancer. Cancer Sci. 98:1720–1726.
2007. View Article : Google Scholar : PubMed/NCBI
|
|
28
|
Jorissen E, Prox J, Bernreuther C, et al:
The disintegrin/metalloproteinase ADAM10 is essential for the
establishment of the brain cortex. J Neurosci. 30:4833–4844. 2010.
View Article : Google Scholar : PubMed/NCBI
|
|
29
|
Jacobsen KT, Adlerz L, Multhaup G and
Iverfeldt K: Insulin-like growth factor-1 (IGF-1)-induced
processing of amyloid-β precursor protein (APP) and APP-like
protein 2 is mediated by different metalloproteinases. J Biol Chem.
285:10223–10231. 2010.
|
|
30
|
Venkataramani V, Rossner C, Iffland L, et
al: Histone deacetylase inhibitor valproic acid inhibits cancer
cell proliferation via down-regulation of the alzheimer amyloid
precursor protein. J Biol Chem. 285:10678–10689. 2010. View Article : Google Scholar : PubMed/NCBI
|
|
31
|
Fan X, Liu Y, Jiang J, et al: miR-20a
promotes proliferation and invasion by targeting APP in human
ovarian cancer cells. Acta Biochim Biophys Sin. 42:318–324. 2010.
View Article : Google Scholar : PubMed/NCBI
|
|
32
|
Pan Y, Han C, Wang C, et al: ADAM10
promotes pituitary adenoma cell migration by regulating cleavage of
CD44 and L1. J Mol Endocrinol. 49:21–33. 2012. View Article : Google Scholar : PubMed/NCBI
|
|
33
|
Anderegg U, Eichenberg T, Parthaune T, et
al: ADAM10 is the constitutive functional sheddase of CD44 in human
melanoma cells. J Invest Dermatol. 129:1471–1482. 2009. View Article : Google Scholar : PubMed/NCBI
|
|
34
|
DeCicco-Skinner KL, Nolan SJ, Deshpande
MM, Trovato EL, Dempsey TA and Wiest JS: Altered prostanoid
signaling contributes to increased skin tumorigenesis in Tpl2
knockout mice. PLoS One. 8:e562122013. View Article : Google Scholar : PubMed/NCBI
|
|
35
|
Massi D, Tarantini F, Franchi A, et al:
Evidence for differential expression of Notch receptors and their
ligands in melanocytic nevi and cutaneous malignant melanoma. Mod
Pathol. 19:246–254. 2006. View Article : Google Scholar : PubMed/NCBI
|
|
36
|
Gutwein P, Oleszewski M, Mechtersheimer S,
Agmon-Levin N, Krauss K and Altevogt P: Role of Src kinases in the
ADAM-mediated release of L1 adhesion molecule from human tumor
cells. J Biol Chem. 275:15490–15497. 2000. View Article : Google Scholar : PubMed/NCBI
|